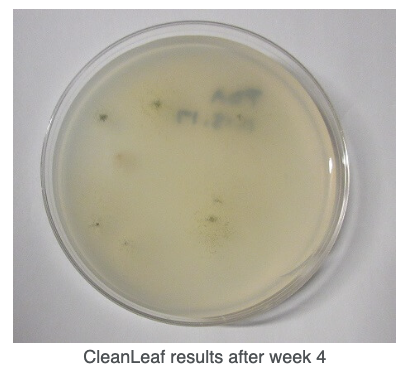
Screen Shot 2026-01-16 at 2.38.26 PM
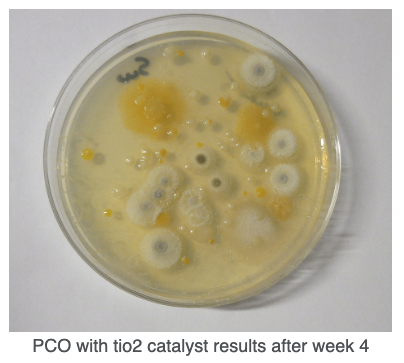
Screen Shot 2026-01-16 at 2.38.36 PM
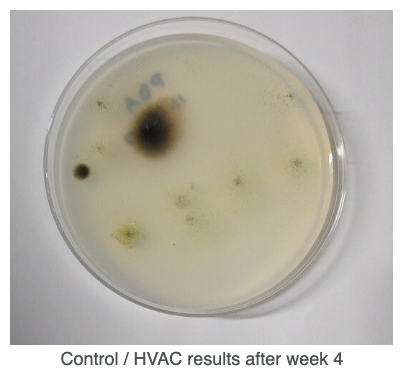
Screen Shot 2026-01-16 at 2.38.45 PM

CleanLeaf Lab Test Results
We sent CleanLeaf Air Filtration Systems to a lab-controlled environment for a 4-week study to test and compare methods.
We decided to share the lab results for full transparency - we want you to know why our systems work and why they are more effective than the other methods.
Having CleanLeaf Air Filtration Systems tested ensures that they meet customer requirements and perform to our manufacturing specifications.
We chose to test CleanLeaf HEPA air filtration systems against HVAC and TiO2 PCO systems to gauge effectiveness and efficiency, below is a summary of the overall lab study + our results!
4 Week Independent Study
I. Room Layout
• 1,000 sq. ft.
• Contains 300 plants
• Environment is controlled and kept around 75° and 50% RH
• In Test Room 1, CleanLeaf units were hung in opposite corners of the room
• In Testing Room 2, PCO units were hung in opposite corners of the room
• The control room relied on HVAC to mitigate microbiological contaminants
II. Testing
The test was completed by loading a Buck Bio Culture pump air sampler for a Potato Dextrose Agar Plate and running the sampler for five minutes in the center of both the testing rooms and the control room.
The first samples were taken five hours after plants had been transferred into the rooms and 24 hours after the maintenance crew completed extensive cleansing.
Each weekly sample was incubated for 5 days before pictures were documented. The samples were incubated in the same room to ensure an accurate representation of growth patterns over the 4-week period.
![]() |
![]() |
![]() |
III. Results
After the testing was completed, CleanLeaf showed minimal colonies of fungus and a drastically lower spore count when compared to HVAC and PCO technologies.
Upon seeing the results, the cannabis production company decided to move forward by outfitting all of their facilities with CleanLeaf HEPA units.
It's too often that grow room air quality is overlooked. Many factors can negatively impact air quality and lead to poor plant conditions in grow spaces. CleanLeaf Air Filtration Systems are designed to capture, control, prevent, and clean airborne threats so that you can focus on other aspects of your business.
You can trust that you'll produce the healthiest crops with CleanLeaf! Get in touch with our specialists today to learn more.
You may also like:
- How Does CleanLeaf Work?
- Case Study: RI's Finest Gardens
- HEPA Air Filtration for Commercial Applications